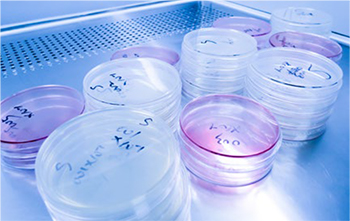
pds_18173103_bild2.jpg

LACTIBIANE Reference V Kapseln
- Anbieter:
- PILEJE Deutschland GmbH
- Darreichungsform:
- Kapseln
- Packungsgröße:
- 30 St
- Artikelnr.:
- 18173103
- Verfügbarkeit:
- ausverkauft
- Ihr Preis:
- 36,95 €4)
- 32,15 €*
- - 13% 2)
- 1,07 € pro 1 Stk
Registrierter Benutzer
Kundenkonto anlegen
Ich bin ein neuer Kunde und möchte meine Adresse für zukünftige Bestellungen hinterlegen.
Anlegen- Detaillierte Produktbeschreibung

Lactibiane® Reference V
Mikrobiotikum auf Basis von 4 mikrobiotischen Stämmen

Gründungspräsident Dr. med. Christian LeclercDr. med. Christian Leclerc, einer der Gründer von PiLeJe, war über 20 Jahre als Allgemeinmediziner tätig und kommt aufgrund seiner Erfahrungen zu der Überzeugung: „Es muss ein anderer therapeutischer Rahmen gefunden werden, um auf die Anliegen der Patienten individuell einzugehen. Die Ernährung soll Grundlage einer neuen Disziplin werden.“
So wurde er Vorreiter bei verschiedensten Gesundheitsthemen. Auch Dank der Forschung von PiLeJe weiß man heute z. B. um die große Bedeutung die Darmflora für die allgemeine Gesundheit. Christian Leclerc bewies auch beim Thema Mikroernährung und Phytotherapie Pioniergeist und entwickelte ganzheitliche Gesundheitslösungen: individualisiert, vorbeugend und ergänzend zur klassischen Medizin. Ein Schwerpunkt liegt darin, den Ursprung der Beschwerden zu verstehen und dagegen spezifische Inhaltstoffe zu entwickeln. Dr. med. Christian Leclerc sieht seine Herausforderung darin, den Patienten zu helfen, ihre Lebensqualität zu verbessern und den Gesundheitszustand langfristig zu erhalten. Mit dieser Philosophie steht PiLeJe nun seit über 30 Jahren für höchste Produktqualität.
Die Darmflora – ein sensibles Gleichgewicht
Die Darmflora enthält verschiedene Bakterien, wie beispielweise Milchsäurebakterien (Laktobazillen) und Bifidobakterien, welche für die Funktion des Darms eine wichtige Rolle spielen und sich auf vielfältige Weise positiv auf den menschlichen Organismus auswirken. Sie unterstützen zum einen die Verdauung, können zum anderen schädliche Erreger direkt abwehren und sogar verschiedene Vitamine wie Folsäure oder Biotin produzieren. Außerdem werden im Darm eine ganze Reihe unserer Hormone („Botenstoffe“) produziert.
Dazu gehören unter anderem die Glückshormone Dopamin und Serotonin, und auch vom Schlafhormon Melatonin findet man im Darm hohe Konzentrationen. Es gibt unterschiedliche Gründe, warum dieses sensible Gleichgewicht im Darm durcheinandergeraten kann. Beispielsweise haben erbliche Einflussfaktoren, Stress und Antibiotikaeinnahme einen enormen Einfluss auf das Mikrobiom im Darm und können dazu führen, dass sich schädliche Bakterien stärker vermehren und zu Blähbauch, Verstopfung, Bauchschmerzen, Verdauungsbeschwerden und letztlich Entzündungen führen.
Da Darmbakterien die Bewegungen der Darmmuskulatur stimulieren, kann eine Störung der Darmflora zu einer verlangsamten Darmbewegung führen. Die verlängerte Passage durch den Dickdarm entzieht der Nahrung Wasser, wodurch Verstopfung auftritt. Diese Beschwerden treten auch beim sogenannten Reizdarmsyndrom auf. Auch hier ist die Darmflora gestört, sodass ein Ungleichgewicht der Darmbakterien herrscht. Man spricht dann von einer sogenannten Dysbiose. Ebenfalls spielt die Ernährung eine entscheidende Rolle, denn auch eine unausgewogene Ernährung bringt das Darmmikrobiom aus der Bahn.
Hingegen unterstützt eine ausgewogene Ernährung den Aufbau der Darmflora und die Ansiedlung geeigneter Bakterienstämme. Entsprechende Bakterienstämme können auch separat zugeführt werden, beispielsweise mit Lactibiane® Reference V.
Nützliche Milchsäurebakterien
Milchsäurebakterien unterstützen das Immunsystem und zählen zu den nützlichen Bakterien der Darmflora. Sie erfüllen dort zahlreiche wichtige Aufgaben. Sie verdrängen schädliche Bakterien und bilden Stoffe, um Krankheitserreger zu bekämpfen. Des weiteren produzieren sie Milchsäure und erhalten damit ein leicht saures Milieu im Darm, wodurch die Ansiedlung schädlicher Keime zusätzlich erschwert wird. Zudem stärken sie die Darmbarriere.
Damit nicht genug, verbessern Laktobazillen die Verwertbarkeit von lebenswichtigen Nährstoffen, sodass diese vom Körper leichter verdaut und aufgenommen werden können. Entsprechende Bakterienstämme können auch separat zugeführt werden, beispielsweise mit Lactibiane® Reference V, das Milchsäurebakterien und Bifidobakterien enthält.
Abwehr von schädlichen Erregern durch Bifidobakterien
Bifidobakterien gehören ebenfalls zu den wichtigen Mikroorganismen der Darmflora. Da Bifidobakterien keinen Sauerstoff benötigen, besiedeln sie bevorzugt den Dickdarm, während Milchsäurebakterien eher im Dünndarm vertreten sind. Bifidobakterien bilden das Toxin Bifidin und senken den pH-Wert im Dickdarm. Dadurch verhindern sie das Wachstum und die Vermehrung von Darmbakterien und Krankheitserregern wie Typhus und Paratyphus (Salmonellen), welche Verstopfung verursachen können.
Darmflora stärken mit Bakterienstämmen
Ist die Darmflora aufgrund schädlicher Bakterien aus dem Gleichgewicht geraten, helfen bestimmte Bakterien diese wieder aufzubauen. Lebende Bakterienstämme sind natürlich vorkommende nützliche Bakterien, die sich bereits ab dem Zeitpunkt unserer Geburt im Körper befinden. Für eine geeignete Darmsanierung eignet sich daher eine Kombination bestimmter Milchsäure- und Bifidobakterien.
In Lactibiane® Reference V sind die 4 mikrobiotischen Stämme Bifidobacterium longum LA101, Lactobacillus helveticus LA102, Lactobacillus lactis LA103, Streptococcus thermophilus LA104 enthalten. Die Hartkapsel als Darreichungsform ermöglicht eine unkomplizierte einmal tägliche Einnahme auch unterwegs und stellt zugleich die Stabilität und Funktionalität der Bakterienstämme bis zu ihrem Zielort im Organismus sicher.
Auch an die innere Balance denken
Bei häufiger Verstopfung kann sich die Störung der Darm-Hirn-Achse auf die Stimmung niederschlagen. Melioran® kann mit seiner ausgeklügelten Kombination von Phytonährstoffen aus Rosenwurz und Safran für eine emotionale Balance sorgen und zu mehr Gelassenheit und Ausgeglichenheit führen.
Bei Schlafstörungen kann Chronobiane® Melatonin sofort unterstützen, indem gesunder Schlaf durch die Verkürzung der Einschlafzeit gefördert wird. Chronobiane® Melatonin Retard erleichtert dank spezieller Technik mit verzögerter Wirkststoffreisetzung das Einschlafen bei nächtlichem Aufwachen.
ANWENDUNGSEMPFEHLUNG
1 Kapsel pro Tag mit einem großen Glas Wasser einnehmen. Vor einer Mahlzeit einnehmen.
• Mikrobiotikum mit 4 nützlichen Bakterienstämmen
Dauer der Anwendung: 1 Monat
Aufbewahrung: An einem kühlen und trockenen Ort.

RICHTIGE EINNAHME VON MIKROBIOTIKA:
• Idealerweise auf nüchternen Magen einnehmen
• Mit einem Glas Wasser einnehmen
• In ausreichendem zeitlichem Abstand zum Antibiotikum einnehmen
• Mikrobiotische Nahrungsmittel unterstützen den Aufbau der Darmflora
HQM-CHARTA (HOHE MIKROBIOLOGISCHE QUALITÄT)
PiLeJe fordert strenge Kriterien bei der Auswahl seiner probiotischen Stämme und hat eine dem Unternehmen eigene Qualitäts-Charta für die guten Auswahlpraktiken und die Herstellung der Bakterienstämme definiert. Diese gilt als Qualitätsgarantie der mikrobiotischen Gesundheitspräparate und zeigt die im Laufe der langjährigen Forschungstätigkeit an Probiotika erworbenen Kompetenzen auf. Die Einhaltung der Qualitätsrichtlinien kann aufgrund der unternehmenseigenen Produktion sichergestellt werden, die alle Schritte der Mikrobiotika-Herstellung umfasst.

WEITERE TIPPS:
• gesunde, zuckerfreie und ballaststoffreiche Ernährung
• probiotische Lebensmittel einplanen
• Stress vermeiden
• Mahlzeiten langsam essen und gut kauen
• ausreichend trinken
• Alkohol, Tee und Kaffee möglichst reduzieren
• stark gewürzte oder scharfe Lebensmittel meiden
• Regelmäßige Bewegung an der frischen Luft
HÄUFIGE FRAGEN & ANTWORTEN
Welcher Inhaltsstoff ist in Lactibiane® Reference V enthalten?
Milchsäurebakterien 10.109 KBE
Füllmittel: Maisstärke,Kapsel pflanzlicher Herkunft, Milchsäurebakterien, Trennmittel: Fettsäuren.
Wie ist Lactibiane® Reference V einzunehmen?
Von Lactibiane® Reference V ist täglich 1 Kapsel mit einem großen Glas Wasser einzunehmen.
Wie lange ist Lactibiane® Reference V einzunehmen?
Die Dauer der Anwendung entspricht einer Packung mit 30 Kapseln und damit 1 Monat.
Bildquellen: iStockphoto.com/evgenyatamanenko, iStockphoto.com/Nastia11, iStockphoto.com/LeafenLin, iStockphoto.com/stockfour
Da bei rezeptpflichtigen Medikamenten das Originalrezept bei uns vorliegen muss, ist eine Bestellung über das Internet leider nicht möglich. Bitte senden Sie Ihr Rezept daher im Freiumschlag an:
Luitpold Apotheke
Postfach 1360
95148 Selbitz
Einen Freiumschlag können Sie hier bestellen.
Aus Sicherheitsgründen erfolgt kein Versand von Medikamenten die der BTM-Verordnung unterliegen. Kühlpflichtige Medikamente versenden wir von Montag bis Donnerstag.
Nach Eingang und Prüfung des Rezeptes erhalten Sie Ihre Medikamente versandkostenfrei innerhalb von zwei bis drei Werktagen an Ihre angegebene Adresse zugesandt.
Preise für verschreibungspflichtige Arzneimittel
Die Preise für rezeptpflichtige Produkte unterliegen in Deutschland der sog. Preisspannenverordnung, d.h. dass die Preise gesetzlich vorgeschrieben sind und Rabatte nicht gewährt werden dürfen.
Zuzahlungen
Als deutsche Apotheke unterliegen wir deutschem Recht und müssen die gesetzlich vorgeschriebene Zuzahlung in voller Höhe berechnen.
Abrechnung mit den Krankenkassen / Krankenversicherern
- Gesetzlich Versicherte
Wir rechnen direkt mit Ihrer Krankenkasse ab. Sie erhalten eine Rechnung über die von Ihnen geleisteten Zuzahlungen, die Sie ggf. Ihrer Krankenkasse zur Beantragung einer Befreiung einreichen können. - Privat Versicherte
Sie erhalten das Originalrezept und eine Kopie des Rezeptes gestempelt und unterschrieben von uns zurück. Eine Rechnung, die Sie bei Ihrem Versicherer einreichen können, liegt der Sendung bei.
